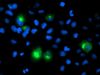

PTP1B (PTPN1) Mouse Monoclonal Antibody [Clone ID: OTI1D10]
CAT#: TA503310
PTPN1 (PTP1B) mouse monoclonal antibody, clone OTI1D10 (formerly 1D10)
Size: 30 ul
Formulation: Carrier Free
View other "OTI1D10" antibodies (2)
Special Offer: Get a 15% discount on this product. Use code: “NEURO15".
USD 823.00
USD 436.00
Specifications
| Product Data | |
| Clone Name | OTI1D10 |
| Applications | FC, IF, IHC, WB |
| Recommended Dilution | WB 1:500~2000, IHC 1:150, IF 1:100, FLOW 1:100 |
| Reactivities | Human, Dog, Monkey, Rat |
| Host | Mouse |
| Isotype | IgG2a |
| Clonality | Monoclonal |
| Immunogen | Full length human recombinant protein of human PTPN1(NP_002818) produced in HEK293 cell. |
| Formulation | PBS (pH 7.3) containing 1% BSA, 50% glycerol and 0.02% sodium azide. |
| Concentration | 1 mg/ml |
| Purification | Purified from mouse ascites fluids or tissue culture supernatant by affinity chromatography (protein A/G) |
| Conjugation | Unconjugated |
| Storage | Store at -20°C as received. |
| Stability | Stable for 12 months from date of receipt. |
| Predicted Protein Size | 49.8 kDa |
| Gene Name | protein tyrosine phosphatase non-receptor type 1 |
| Database Link | |
| Background | The protein encoded by this gene is the founding member of the protein tyrosine phosphatase (PTP) family, which was isolated and identified based on its enzymatic activity and amino acid sequence. PTPs catalyze the hydrolysis of the phosphate monoesters specifically on tyrosine residues. Members of the PTP family share a highly conserved catalytic motif, which is essential for the catalytic activity. PTPs are known to be signaling molecules that regulate a variety of cellular processes including cell growth, differentiation, mitotic cycle, and oncogenic transformation. This PTP has been shown to act as a negative regulator of insulin signaling by dephosphorylating the phosphotryosine residues of insulin receptor kinase. This PTP was also reported to dephosphorylate epidermal growth factor receptor kinase, as well as JAK2 and TYK2 kinases, which implicated the role of this PTP in cell growth control, and cell response to interferon stimulation. [provided by RefSeq] |
| Synonyms | PTP1B |
| Reference Data | |
| Protein Families | Druggable Genome, Phosphatase, Transmembrane |
| Protein Pathways | Adherens junction, Insulin signaling pathway |
Documents
| Product Manuals |
| FAQs |
| SDS |
Resources
| Antibody Resources |
{0} Product Review(s)
Be the first one to submit a review






























































































































































































































































 Germany
Germany
 Japan
Japan
 United Kingdom
United Kingdom
 China
China